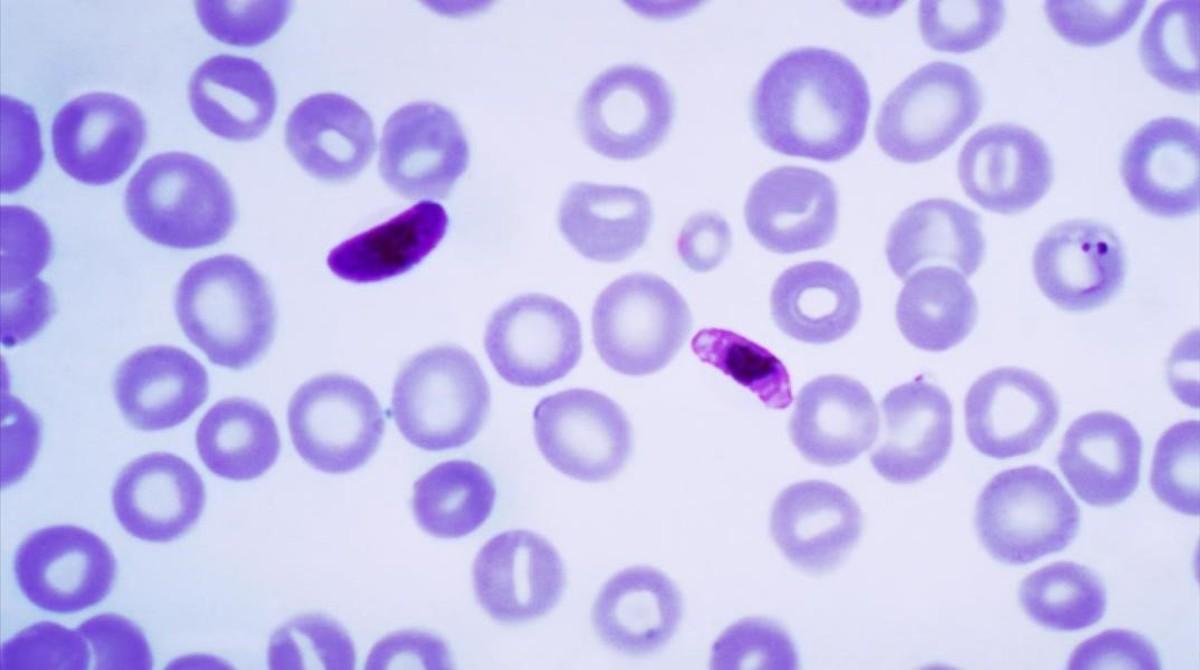
Imagen al microscopio de un protozoo parásito.

SEGÚN UN ESTUDIO
Si tienes este parásito tienes más posibilidades de emprender
Un informe publicado en la Royal Society indica que características como la emprendeduría o la audacia por el riesgo podrían estar relacionados con la presencia de este parásito
Imagen al microscopio de un protozoo parásito. / .30085991
¿Creías que tu pasión por la emprendeduría o tu audacia la llevabas en el ADN? Según un estudio publicado este miércoles en la revista británica Royal Society, eso no es del todo cierto, sino que más bien, podrías tener en tu organismo un parásito llamado toxoplasma.
Este protozoo, científicamente conocido como Toxoplasma gondii, se propaga sobre todo con el consumo de carne cruda o poco cocinada o estando en contacto con materiales contaminados con excrementos de gato, y podría ser el responsable de algunas de las características de las que muchos empresarios se sienten orgullosos.
Casi el doble de emprendedores
Tras haber analizado a más de mil quinientos estudiantes estadounidenses, los responsables del estudio han concluido que los portadores de este parásito eran "1'7 veces más propensos a manifestar interés por la emprendudría y el management que las personas que no lo portaban". Según han argumentado en el mismo estudio, este hecho podría deberse a los cambios hormonales y neurológicos que este protozoo provoca en los humanos.
Según han concluido las universidades implicadas en este estudio, entre las que se encuentra la Universidad de Bilbao, este microorganismo podría ser responsable de la amplificación de la impulsividad, la ambición y la búsqueda de bienes materiales.
- Eclipse lunar y luna de sangre 2026, los dos fenómenos astronómicos que llegan este 3 de marzo
- Presentarse a oposiciones pasados los 50: 'No quiero volver a ser despedida de un trabajo basura
- Evacuado un tren con 50 pasajeros tras quedar parado entre Portbou y Figueres
- La presencia de fósforo se enquista en el embalse del Foix y obliga a acelerar el plan de mejora
- Elena Bianca Ciobanu, la nota más alta del MIR en España: 'Tengo 41 años y he llegado hasta aquí con mucho esfuerzo
- España busca a 30 'astronautas junior' que quieran vivir un día en microgravedad y ser 'embajadores del espacio' durante un año
- Puente propone 'elevar' algunos puntos de la R1 para protegerla de los temporales
- La baliza V16 de la DGT tiene otro problema: 'Es posible que, cuando la necesitemos, no funcione